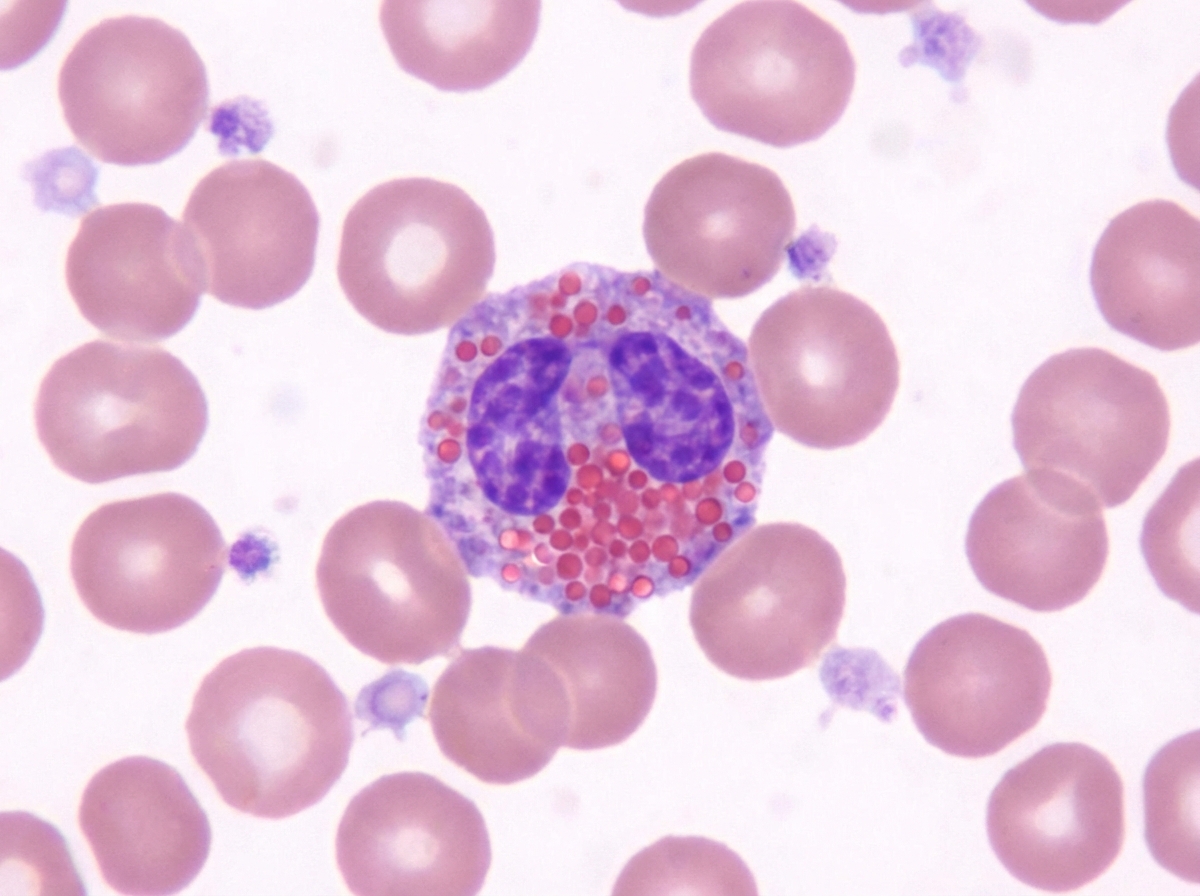
Image for question 102

Lipofuscin is associated with which type of atrophy?
Which cytokine activates the given cell?
A Warthin's tumour is:
Which of the following is NOT a chromosomal breakage syndrome?
All of the following lesions may be classified as odontogenic tumours EXCEPT?
Which finding on electron microscopy indicates irreversible cell injury?
A 32-year-old woman with poorly controlled diabetes mellitus delivers a healthy boy at 38 weeks of gestation. As a result of maternal hyperglycemia during pregnancy, what morphologic response would be expected in the pancreatic islets of the neonate?
Elevated alpha-fetoprotein (AFP) levels are seen in all of the following conditions except?
Annexin V is a marker of which of the following?
Intermediate filaments (IFs) help link adjacent sarcomeres together in skeletal muscle. Which of the following proteins is an intermediate filament protein used diagnostically in pathologic cases to indicate muscle origin?
Explanation: **Explanation:** **Lipofuscin** is an insoluble, brownish-yellow granular intracellular pigment known as the **"wear-and-tear"** or "aging" pigment [1]. It is a hallmark of free radical injury and lipid peroxidation of subcellular membranes [3][4]. **1. Why Brown Atrophy is Correct:** When organs undergo chronic atrophy (due to aging or reduced nutrition), cells shrink and accumulate autophagic vacuoles [2]. These vacuoles contain debris from lipid peroxidation that cannot be fully digested, resulting in the accumulation of Lipofuscin [4]. When present in large amounts, particularly in the **heart (myocardium)** and **liver**, it imparts a distinct brownish discoloration to the shrunken organ [1]. This gross morphological appearance is termed **Brown Atrophy**. **2. Why Other Options are Incorrect:** * **White Atrophy (Atrophie Blanche):** This refers to a specific dermatological condition characterized by star-shaped, ivory-white scarred plaques, typically seen in Chronic Venous Insufficiency or livedoid vasculopathy. It is not related to lipofuscin. * **Red Atrophy:** This is not a standard pathological term for atrophy. However, "Red Softening" may refer to hemorrhagic infarction in the brain, and "Nutmeg Liver" involves red congestion, but neither is associated with lipofuscin-mediated atrophy. * **Black Atrophy:** This is not a recognized medical term. Black pigmentation in tissues is usually due to Carbon (Anthracosis), Melanin, or exogenous pigments. **High-Yield NEET-PG Pearls:** * **Composition:** Lipofuscin is a complex of lipids and proteins [1]. * **Stain:** It is naturally pigmented but can be highlighted by **Periodic Acid-Schiff (PAS)** stain. * **Microscopy:** Appears as fine, golden-brown perinuclear granules [1]. * **Clinical Significance:** It is not toxic to the cell itself but serves as a **biomarker for past free radical damage** and cellular aging [4]. It is most commonly seen in permanent cells (neurons and cardiac myocytes) [1]. **References:** [1] Kumar V, Abbas AK, et al.. Robbins and Cotran Pathologic Basis of Disease. 9th ed. Cellular Responses to Stress and Toxic Insults: Adaptation, Injury, and Death, p. 75. [2] Kumar V, Abbas AK, et al.. Robbins and Cotran Pathologic Basis of Disease. 9th ed. Cellular Responses to Stress and Toxic Insults: Adaptation, Injury, and Death, pp. 47-49. [3] Kumar V, Abbas AK, et al.. Robbins and Cotran Pathologic Basis of Disease. 9th ed. Cellular Responses to Stress and Toxic Insults: Adaptation, Injury, and Death, p. 77. [4] Cross SS. Underwood's Pathology: A Clinical Approach. 6th ed. (Basic Pathology) introduces the student to key general principles of pathology, both as a medical science and as a clinical activity with a vital role in patient care. Part 2 (Disease Mechanisms) provides fundamental knowledge about the cellular and molecular processes involved in diseases, providing the rationale for their treatment. Part 3 (Systematic Pathology) deals in detail with specific diseases, with emphasis on the clinically important aspects., pp. 241-242.
Explanation: ***Interleukin-5 (IL-5)*** - **IL-5** is the primary cytokine responsible for **eosinophil activation**, differentiation, and survival from bone marrow precursors. - It specifically promotes **eosinophil recruitment** to tissues and enhances their **degranulation** and cytotoxic functions. *Interleukin-1 (IL-1)* - **IL-1** is a pro-inflammatory cytokine that primarily activates **macrophages** and **endothelial cells**. - It plays a key role in **fever induction** and **acute phase response**, not eosinophil activation. *Interleukin-2 (IL-2)* - **IL-2** is the primary growth factor for **T lymphocytes**, promoting their proliferation and activation. - It has minimal direct effect on **eosinophil function** and is mainly involved in **adaptive immunity**. *Interleukin-6 (IL-6)* - **IL-6** is a pleiotropic cytokine that primarily stimulates **B cell differentiation** and **hepatic acute phase protein synthesis**. - While it has some inflammatory effects, it does not specifically **activate eosinophils** like IL-5 does.
Explanation: **Warthin’s tumour**, also known as **Papillary Cystadenoma Lymphomatosum**, is the second most common benign salivary gland neoplasm. [1] ### **Explanation of the Correct Answer** **Option A** is correct because Warthin’s tumour is histologically characterized by a dual component: a **double layer of oncocytic epithelium** (forming papillary projections into cystic spaces) and a dense **lymphoid stroma** with germinal centers. [1] Due to this unique combination of glandular (adeno-) and lymphoid tissue, it is classically termed an **adenolymphoma**. It occurs almost exclusively in the **parotid gland**, particularly in the superficial lobe or tail. [1] ### **Analysis of Incorrect Options** * **Option B:** Pleomorphic adenoma (Mixed Tumour) is the *most common* benign salivary gland tumour. [2] Unlike Warthin’s, it contains both epithelial and mesenchymal elements (like chondroid or myxoid tissue) and lacks the characteristic lymphoid stroma. * **Option C & D:** Warthin’s tumour is strictly a **benign** lesion. While Mucoepidermoid carcinoma is the most common malignancy of the parotid, and Adenoid cystic carcinoma is common in submandibular glands, Warthin’s does not fall into the carcinoma category. ### **High-Yield NEET-PG Pearls** * **Smoking Link:** It is the only salivary gland tumour strongly associated with **smoking**. * **Demographics:** Typically affects **older males** (though the male-to-female ratio is narrowing). * **Bilateralism:** It is the most common salivary gland tumour to present **bilaterally** (10%) or multicentrically. * **Hot Spot:** On Technetium-99m pertechnetate radionuclide scanning, Warthin’s tumour appears as a **"hot" nodule** (due to mitochondrial accumulation in oncocytes). **References:** [1] Kumar V, Abbas AK, et al.. Robbins and Cotran Pathologic Basis of Disease. 9th ed. Head and Neck, p. 753. [2] Kumar V, Abbas AK, et al.. Robbins and Cotran Pathologic Basis of Disease. 9th ed. Head and Neck, pp. 751-753.
Explanation: **Explanation:** The correct answer is **D. Duchenne muscular dystrophy (DMD).** **1. Why Duchenne Muscular Dystrophy is the correct answer:** Chromosomal breakage syndromes are a group of genetic disorders characterized by **defects in DNA repair mechanisms**, leading to high rates of chromosomal instability, breaks, and rearrangements. DMD, however, is an **X-linked recessive** disorder caused by a mutation (typically a large deletion) in the *DMD* gene encoding the protein **dystrophin** [1, 5]. It is a structural protein defect affecting muscle membrane integrity, not a defect in DNA repair or chromosomal stability. **2. Analysis of Incorrect Options (Chromosomal Breakage Syndromes):** * **A. Fragile X Syndrome:** Characterized by a triplet repeat expansion (CGG) in the *FMR1* gene. It results in a "fragile site" on the X chromosome where the chromatin fails to condense properly during mitosis, leading to breakage. * **B. Bloom Syndrome:** Caused by a mutation in the *BLM* gene (DNA helicase). It is characterized by striking genomic instability and a high frequency of **sister chromatid exchanges (SCE)** [2]. * **C. Ataxia Telangiectasia:** Caused by a mutation in the *ATM* gene, which is responsible for detecting double-stranded DNA breaks [2]. Failure to repair these breaks leads to cerebellar ataxia and oculocutaneous telangiectasia. **3. NEET-PG High-Yield Pearls:** * **Common Feature:** All chromosomal breakage syndromes (including Fanconi Anemia and Xeroderma Pigmentosum) carry a significantly **increased risk of malignancy** (e.g., leukemia, lymphoma, or skin cancer) due to unrepaired DNA damage [2]. * **DMD Diagnosis:** Look for Gowers' sign, pseudohypertrophy of calves, and markedly elevated Creatine Kinase (CK) levels. * **Bloom Syndrome Hallmark:** "Butterfly" rash on the face and "quadriradial" chromosomal configurations. **References:** [1] Kumar V, Abbas AK, et al.. Robbins and Cotran Pathologic Basis of Disease. 9th ed. Peripheral Nerves and Skeletal Muscles, pp. 1244-1245. [2] Kumar V, Abbas AK, et al.. Robbins and Cotran Pathologic Basis of Disease. 9th ed. Neoplasia, pp. 322-323. [3] Cross SS. Underwood's Pathology: A Clinical Approach. 6th ed. (Basic Pathology) introduces the student to key general principles of pathology, both as a medical science and as a clinical activity with a vital role in patient care. Part 2 (Disease Mechanisms) provides fundamental knowledge about the cellular and molecular processes involved in diseases, providing the rationale for their treatment. Part 3 (Systematic Pathology) deals in detail with specific diseases, with emphasis on the clinically important aspects., pp. 58-59.
Explanation: **Explanation:** The correct answer is **Branchial cleft cyst** because it is a developmental cyst of the neck, not an odontogenic tumor. **1. Why Branchial Cleft Cyst is the correct answer:** A branchial cleft cyst (cervical lymphoepithelial cyst) is a **developmental anomaly** arising from the remnants of the second branchial arch (most commonly). It typically presents as a painless, fluctuant mass along the anterior border of the sternocleidomastoid muscle. Since it originates from branchial apparatus remnants rather than the dental lamina or tooth-forming tissues, it is not classified as an odontogenic lesion. **2. Analysis of Incorrect Options:** * **A & D. Ameloblastoma (Acanthomatous and Simple):** Ameloblastoma is the most common clinically significant **odontogenic tumor**. [1] It is benign but locally invasive. [1] "Simple" refers to the classic follicular or plexiform patterns, while "Acanthomatous" is a histological variant characterized by squamous metaplasia with keratin formation within the islands of tumor cells. * **C. Myxoma:** Specifically the **Odontogenic Myxoma**, this is a benign but aggressive mesenchymal tumor derived from the dental papilla, follicle, or periodontal ligament. [1] It has a characteristic "soap bubble" or "honeycomb" appearance on X-ray. **NEET-PG High-Yield Pearls:** * **Most common odontogenic tumor:** Odontoma (often considered a hamartoma); **Ameloblastoma** is the most common true neoplasm. [1] * **Radiological sign of Ameloblastoma:** "Soap bubble" appearance (multilocular radiolucency). * **Branchial Cleft Cyst Location:** Most common at the junction of the upper 1/3 and middle 1/3 of the sternocleidomastoid muscle. * **Histology of Branchial Cleft Cyst:** Lined by stratified squamous epithelium with prominent **subepithelial lymphoid aggregates** (germinal centers). **References:** [1] Kumar V, Abbas AK, et al.. Robbins and Cotran Pathologic Basis of Disease. 9th ed. Head and Neck, pp. 741-742.
Explanation: ### Explanation In cellular pathology, the transition from reversible to irreversible injury is marked by profound membrane damage and severe mitochondrial dysfunction [1]. **Why Option C is Correct:** **Flocculent (amorphous) densities** in the mitochondrial matrix are the hallmark ultrastructural sign of **irreversible cell injury** [1]. These densities represent large, irregular aggregates of denatured proteins and precipitated calcium phosphates. Their presence indicates that the mitochondria have suffered permanent damage and can no longer generate ATP, leading to inevitable cell death (necrosis) [1]. **Analysis of Incorrect Options:** * **A & B: Dilatation of ER and Dissociation of Ribosomes:** These are classic features of **reversible cell injury** [1]. When ATP levels drop, the failure of the Na+/K+ pump leads to an influx of water (cellular swelling/hydropic change), causing the ER to cisternae to dilate [2]. This swelling causes ribosomes to detach, leading to decreased protein synthesis. Both processes can be reversed if oxygenation is restored. * **D: Myelin Figures:** These are whorled phospholipid masses derived from damaged cell membranes [1]. While they are prominent in irreversible injury, they **first appear during the reversible stage** [1]. Therefore, they are not a definitive indicator of irreversibility. **NEET-PG High-Yield Pearls:** 1. **Point of No Return:** The two consistent markers of irreversibility are the **inability to reverse mitochondrial dysfunction** and **profound disturbances in membrane function** [2]. 2. **Mitochondrial Changes:** Small, "clear" vacuoles in mitochondria are reversible; large, "flocculent" densities are irreversible [1]. 3. **Nuclear Changes:** Irreversibility is confirmed light microscopically by nuclear changes: **Pyknosis** (shrinkage), **Karyorrhexis** (fragmentation), and **Karyolysis** (dissolution). 4. **Earliest Change:** The earliest change in most forms of cell injury (like ischemia) is a decrease in ATP production [2]. **References:** [1] Kumar V, Abbas AK, et al.. Robbins and Cotran Pathologic Basis of Disease. 9th ed. Cellular Responses to Stress and Toxic Insults: Adaptation, Injury, and Death, pp. 53-55, 61-62. [2] Kumar V, Abbas AK, et al.. Robbins and Cotran Pathologic Basis of Disease. 9th ed. Cellular Responses to Stress and Toxic Insults: Adaptation, Injury, and Death, pp. 60-61.
Explanation: **Explanation:** **Correct Answer: C. Hyperplasia** The underlying mechanism in this scenario is the **Pedersen Hypothesis**. During pregnancy, maternal hyperglycemia leads to high levels of glucose crossing the placenta (via GLUT-1 transporters). However, maternal insulin does not cross the placenta. The fetal pancreas responds to this persistent glycemic load by increasing the number of insulin-producing beta cells to maintain euglycemia. This increase in the number of cells in an organ is defined as **hyperplasia** [1]. Post-delivery, these neonates are at high risk of transient **neonatal hypoglycemia** because their hyperplastic islets continue to secrete high levels of insulin [2] even after the maternal glucose supply is severed. **Why other options are incorrect:** * **Atrophy:** This refers to a decrease in cell size or number. In this case, the islets are overstimulated, not underutilized or deprived of nutrients. * **Dysplasia:** This involves disordered growth and maturation of epithelium (atypical features). It is a pre-neoplastic change and does not occur in response to metabolic stimulation in the pancreas. * **Metaplasia:** This is the reversible conversion of one adult cell type to another (e.g., columnar to squamous). The islet cells remain beta cells; they simply increase in number. **High-Yield Clinical Pearls for NEET-PG:** * **Islet Cell Hyperplasia** is the classic pancreatic finding in infants of diabetic mothers (IDM). * **Macrosomia:** Hyperinsulinemia acts as a growth factor, leading to increased fetal size. * **Other common associations in IDM:** Caudal regression syndrome (most specific), Transposition of Great Arteries (TGA), and Respiratory Distress Syndrome (due to insulin inhibiting surfactant production). **References:** [1] Cross SS. Underwood's Pathology: A Clinical Approach. 6th ed. (Basic Pathology) introduces the student to key general principles of pathology, both as a medical science and as a clinical activity with a vital role in patient care. Part 2 (Disease Mechanisms) provides fundamental knowledge about the cellular and molecular processes involved in diseases, providing the rationale for their treatment. Part 3 (Systematic Pathology) deals in detail with specific diseases, with emphasis on the clinically important aspects., pp. 85-87. [2] Cross SS. Underwood's Pathology: A Clinical Approach. 6th ed. Common Clinical Problems From Liver And Biliary System Disease, pp. 433-435.
Explanation: **Explanation:** Alpha-fetoprotein (AFP) is a glycoprotein normally produced by the fetal liver and yolk sac. In adult pathology, it serves as a crucial tumor marker for specific germ cell tumors and hepatocellular carcinomas. **Why "None of the above" is correct:** The question asks which condition does *not* show elevated AFP. However, all three listed conditions (Hepatoblastoma, Seminoma, and Teratoma) can be associated with elevated AFP levels under specific circumstances, making "None of the above" the technically correct choice in this context. **Analysis of Options:** * **Hepatoblastoma (A):** This is the most common primary liver tumor in children. AFP is a highly sensitive marker for this condition, with levels often being extremely high at diagnosis. * **Seminoma (B):** This is a high-yield point for NEET-PG. While **pure** seminomas typically show normal AFP levels, approximately 10–15% of cases contain "occult" yolk sac elements or are part of a mixed germ cell tumor, leading to AFP elevation [1]. If a biopsy shows seminoma but AFP is elevated, it is clinically treated as a non-seminomatous germ cell tumor (NSGCT) [2]. * **Teratoma (C):** Mature or immature teratomas are often part of mixed germ cell tumors [1]. If they coexist with yolk sac tumor components (which is common), AFP levels will be significantly elevated [2]. **NEET-PG High-Yield Pearls:** 1. **Yolk Sac Tumor (Endodermal Sinus Tumor):** Shows the highest elevation of AFP; Schiller-Duval bodies are the characteristic histological finding. 2. **Hepatocellular Carcinoma (HCC):** AFP is used for screening and monitoring recurrence. 3. **Neural Tube Defects (NTD):** Elevated AFP in maternal serum/amniotic fluid indicates NTDs (e.g., Anencephaly, Spina bifida), while **decreased** AFP is associated with Down Syndrome (Trisomy 21). 4. **Rule of Thumb:** If AFP is elevated in a suspected testicular tumor, it *cannot* be a pure seminoma; it must contain yolk sac elements [2]. **References:** [1] Kumar V, Abbas AK, et al.. Robbins and Cotran Pathologic Basis of Disease. 9th ed. The Lower Urinary Tract and Male Genital System, pp. 979-980. [2] Cross SS. Underwood's Pathology: A Clinical Approach. 6th ed. Common Clinical Problems From Diseases Of The Urinary And Male Genital Tracts, pp. 512-513.
Explanation: **Explanation:** **Annexin V** is a cellular protein with a high affinity for **Phosphatidylserine (PS)**. In healthy cells, PS is strictly maintained on the inner leaflet (cytoplasmic side) of the plasma membrane by the enzyme flippase. One of the earliest biochemical features of **apoptosis** is the loss of membrane asymmetry, where PS "flips" to the outer leaflet [1]. This serves as an "eat-me" signal for phagocytes [1], [2]. Because Annexin V binds specifically to PS, it is used as a sensitive laboratory marker to identify and quantify apoptotic cells via flow cytometry. **Analysis of Incorrect Options:** * **B. Necrosis:** While the membrane eventually ruptures in necrosis, the specific "flipping" of PS is a regulated hallmark of programmed cell death (apoptosis). In late necrosis, Annexin V might bind to the internal PS of a ruptured cell, but it is not a diagnostic marker for the process itself. * **C. Atherosclerosis:** Although apoptosis occurs within atherosclerotic plaques, Annexin V is not a clinical marker used to diagnose or monitor the progression of atherosclerosis. * **D. Inflammation:** Inflammation is a systemic or local response to injury. While apoptosis can occur during the resolution of inflammation, Annexin V is specific to the cellular process of apoptosis, not the inflammatory cascade. **High-Yield NEET-PG Pearls:** * **Flippase vs. Scramblase:** In apoptosis, flippase is inactivated and **scramblase** is activated, leading to the externalization of Phosphatidylserine [1]. * **Phagocytosis:** Externalized PS allows for the clearance of apoptotic bodies without inducing an inflammatory response (unlike necrosis) [2]. * **Flow Cytometry:** Annexin V is often used in conjunction with **Propidium Iodide (PI)**. Annexin V+/PI- cells are in early apoptosis, while Annexin V+/PI+ cells are in late apoptosis/necrosis. **References:** [1] Kumar V, Abbas AK, et al.. Robbins and Cotran Pathologic Basis of Disease. 9th ed. With Illustrations By, pp. 19-20. [2] Kumar V, Abbas AK, et al.. Robbins and Cotran Pathologic Basis of Disease. 9th ed. Cellular Responses to Stress and Toxic Insults: Adaptation, Injury, and Death, pp. 67-69.
Explanation: **Explanation:** Intermediate filaments (IFs) are essential components of the cytoskeleton that provide mechanical strength to cells. In muscle tissue (skeletal, cardiac, and smooth), the primary intermediate filament protein is **Desmin**. 1. **Why Desmin is Correct:** Desmin forms a lattice that surrounds the Z-discs of sarcomeres, linking them to each other and to the plasma membrane (sarcolemma). In diagnostic pathology, Desmin is a highly specific **Immunohistochemical (IHC) marker**. Its presence is used to identify tumors of muscle origin, such as **Rhabdomyosarcoma** (skeletal muscle) or **Leiomyosarcoma** (smooth muscle). 2. **Analysis of Incorrect Options:** * **Actin (A):** While actin is a major contractile protein in muscle, it is classified as a **microfilament** (6-7 nm), not an intermediate filament (10 nm). * **Actinin (C):** Alpha-actinin is an anchoring protein found in the Z-discs that binds actin filaments; it is not an intermediate filament. * **Clathrin (D):** This is a protein involved in the formation of coated vesicles for **receptor-mediated endocytosis**, unrelated to the muscle cytoskeleton. **High-Yield Clinical Pearls for NEET-PG:** * **Vimentin:** The IF marker for mesenchymal cells (connective tissue, sarcomas). * **Cytokeratin:** The IF marker for epithelial cells (carcinomas). * **GFAP:** The IF marker for glial cells (astrocytomas). * **Neurofilaments:** The IF marker for neurons (neuroblastoma, pheochromocytoma). * **Mallory-Denk Bodies:** These are inclusions found in alcoholic liver disease composed of pre-keratin intermediate filaments.
Cell Injury and Cell Death
Practice Questions
Adaptations of Cellular Growth
Practice Questions
Accumulations and Deposits
Practice Questions
Acute and Chronic Inflammation
Practice Questions
Tissue Repair and Wound Healing
Practice Questions
Hemodynamic Disorders
Practice Questions
Genetic Disorders
Practice Questions
Environmental Pathology
Practice Questions
Nutritional Diseases
Practice Questions
Molecular Basis of Disease
Practice Questions
Get full access to all questions, explanations, and performance tracking.
Start For Free